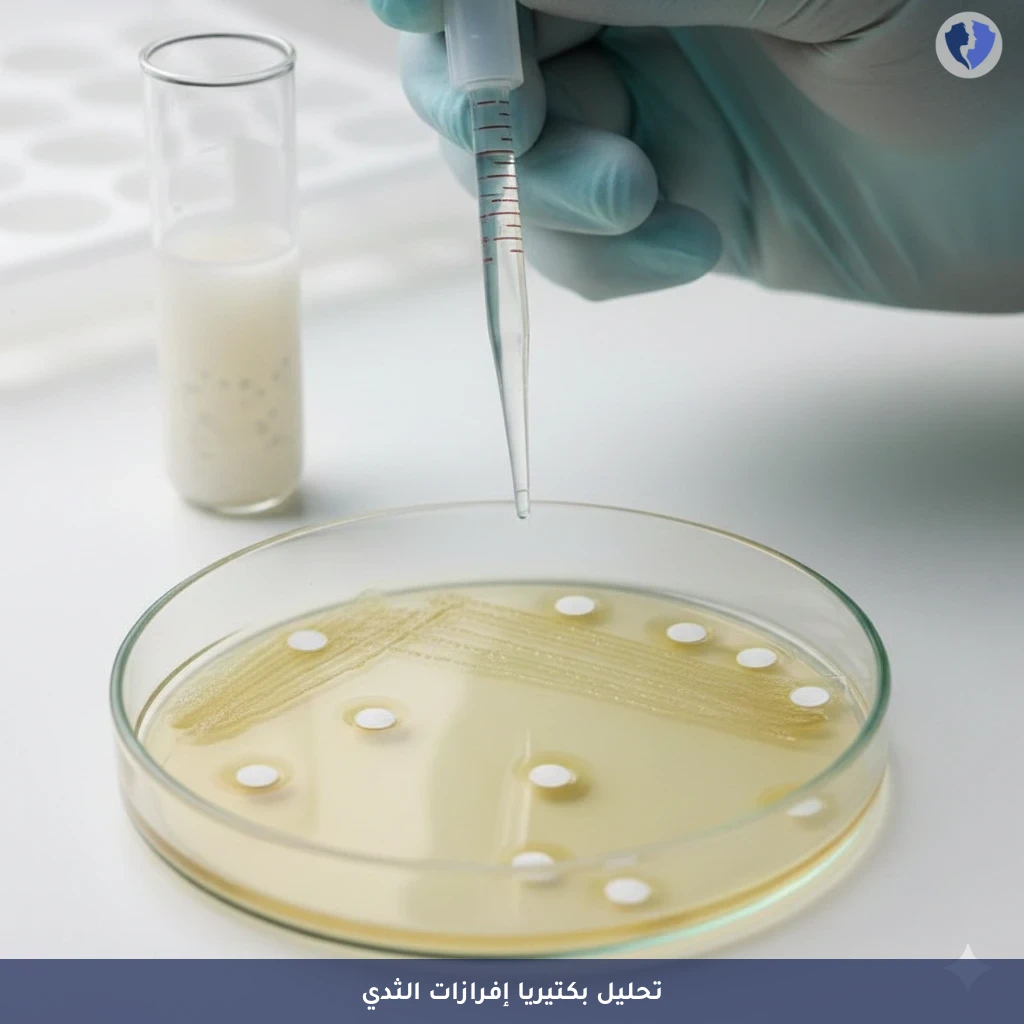
تحليل إفرازات الثدي والمزرعة - مزرعة وحساسية إفرازات الحلمة (Nipple Discharge Culture)

تفاصيل الخدمة
تحليل إفرازات الثدي والمزرعة - مزرعة وحساسية إفرازات الحلمة (Nipple Discharge Culture)
فحص ميكروبيولوجي يتم فيه جمع عينة من الإفرازات غير الطبيعية للحلمة (مثل الصديد أو الإفرازات الملونة) وزراعتها على أوساط غذائية انتقائية للبكتيريا الهوائية واللاهوائية، وكذلك للفطريات في بعض الحالات. الهدف الأساسي هو عزل وتحديد الكائنات الحية الدقيقة المسببة للعدوى (مثل المكورات العنقودية الذهبية، المكورات العقدية، أو الإشريكية القولونية). كما يتضمن الفحص إجراء اختيار الحساسية للمضادات الحيوية (Antibiogram) على البكتيريا المعزولة لتوجيه العلاج الدوائي الأمثل.